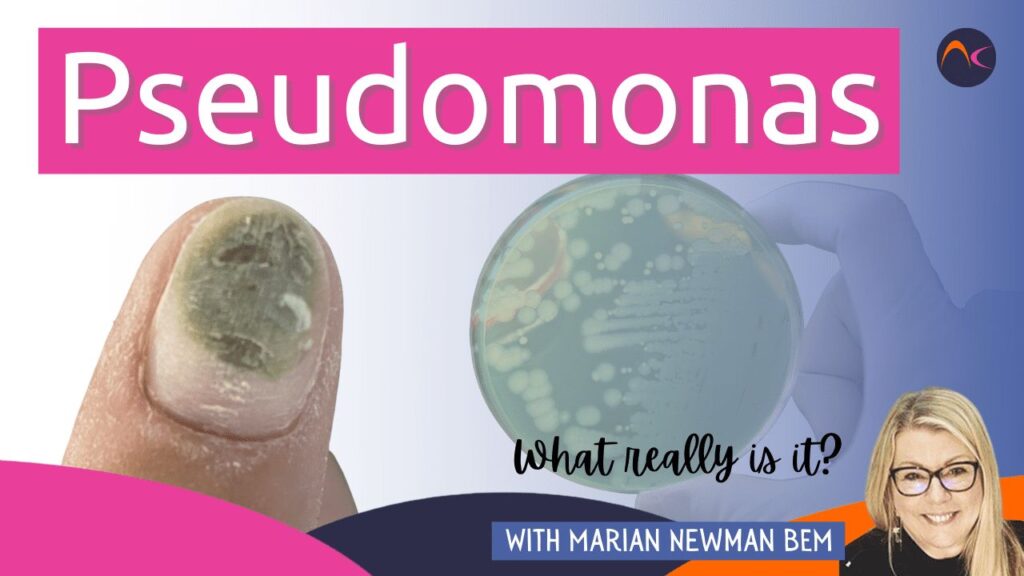
Pseudomonas

While numerous blogs on NailKnowledge have discussed the issue of ‘greenies,’ it remains a prevalent concern for nail professionals. Recent developments, such as the increased use of hand sanitisers, evolving nail conditions, and allergies, have made it even more pressing. Thus, we present another informative piece, shedding light on the facts surrounding ‘greenies’ and their link to Pseudomonas.
Pseudomonas y Greenies
At NailKnowledge, we cannot stress enough about the relatively new evidence about ‘greenies’. It does not necessarily die when exposed to air; there can be secondary infections present; it should not be covered with a semi-permanent coating.

Let me share a little about the bacterium itself. Pseudomonas is a bacteria, in various forms, that causes many different conditions. It is a problem in many hospitals as it is connected with MRSA (methicillin-resistant Staphylococcus aureus) It has been called a ‘super-bug’ as it is so resistant to treatments.
Many still believe that you can file/buff the ‘greenie’ away and it will be fine. But buffing a nail with this infection puts the bacteria into the environment and, one of it’s most common problems, is lung infections. For example, pneumonia! This is a condition that is particularly relevant to COVID-19 but is dangerous at any time.
Está relacionado con otros problemas, como la infección de heridas (de ahí la conexión con el SARM), la septicemia, las infecciones del tracto urinario y las infecciones gastrointestinales.
It may have been seen as a ‘minor’ nail condition caused by lifted product where water seeps in. But it is actually far more serious than that.
It can destroy the nail plate when it takes hold. This will expose the protein in the plate i.e., keratin and this can lead to more infections that become more difficult to treat. It can result in the surgical removal of the nail plate in order to control the infections.
So, what is the solution? Thorough preparation of the nail plate is a starting point that will help to avoid any lifting. Education of the client to understand that opaque coatings need a regular (2-3 week) removal in order to check for any problems. Plus understanding that ANY discolouration or any discomfort needs to be checked by the nail pro.
For those that say “I’ve reapplied coatings with no problem” have been lucky! It must be taken seriously. Pathogens are known as becoming more resistant to usual treatments. Also, any infection of the nail plate takes a long time to resolve.
Take your career seriously and understand what can and does affect the health of your client’s nail, skin, and general health.